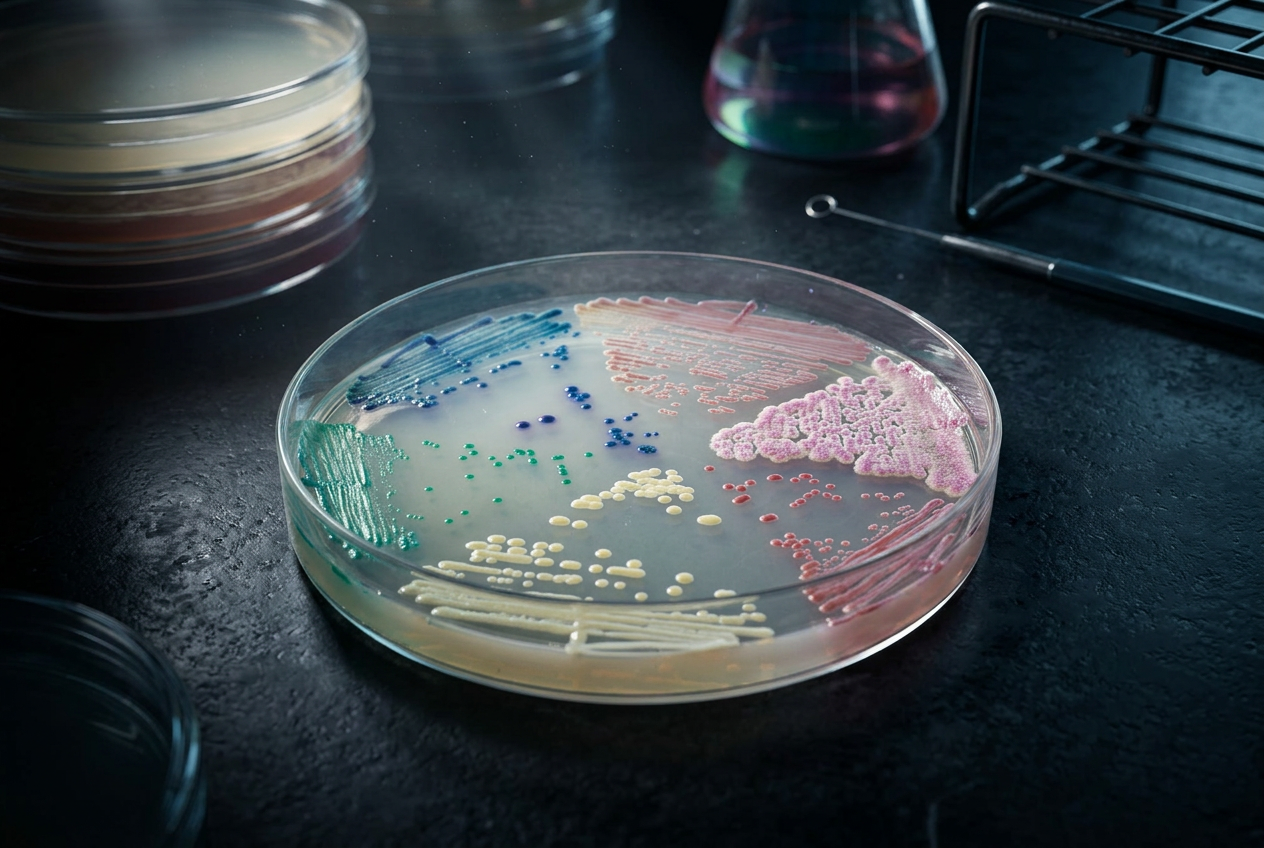
CHROMAGAR CANDIDA 1000ML

Insumos y Reactivos
Todo lo que se gasta o se repone en la operación diaria.
14 productos
Bolsas Estériles - Muestreo
Bolsas estériles para recolección y transporte de muestras para análisis.
Medios de cultivo
Medios de cultivo y reactivos para microbiología.
Estériles y Control
Monitoreo de procesos térmicos y de esterilidad.
Recipientes
Frascos y recipientes para muestras, incluyendo frascos con tiosulfato y otros recipientes de laboratorio.
Soluciones para micotoxinas
Reactivos y soluciones para análisis de micotoxinas.
Soluciones para análisis de agua
Reactivos y sistemas para análisis microbiológico de agua.
Kit de Diagnóstico de Enfermedades
Kits de diagnóstico para detección de enfermedades aviares y porcinas